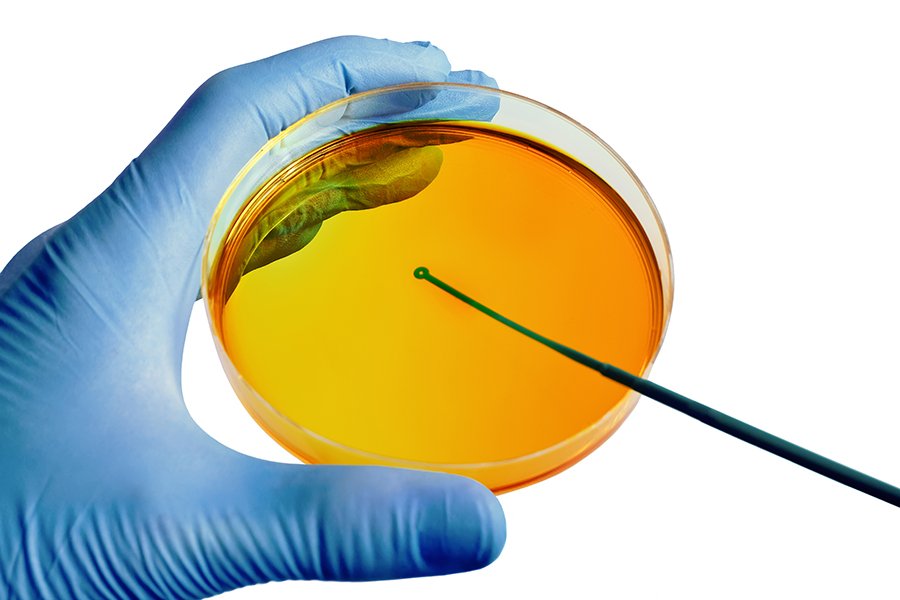
Fazendo cultura microbiológica em pote

No atendimento odontopediátrico, é comum que os profissionais se deparem com crianças apresentando lesões dolorosas na mucosa bucal, acompanhadas de febre e dificuldade para se alimentar.
Esses quadros frequentemente estão relacionados à estomatite infantil, uma condição que exige diagnóstico preciso e conduta clínica adequada.
Mais do que um simples desconforto passageiro, a estomatite pode comprometer a saúde geral e o bem-estar da criança, interferindo em aspectos como nutrição, sono e até mesmo no comportamento.
Para o cirurgião-dentista, compreender os mecanismos fisiopatológicos, as causas e os tratamentos é essencial para oferecer uma abordagem terapêutica segura e eficaz.
Neste artigo, você confere uma análise técnica e aprofundada sobre a estomatite infantil, com foco nas suas principais causas, métodos diagnósticos e condutas terapêuticas baseadas em evidências clínicas.

O que é estomatite infantil?
A estomatite infantil é um processo inflamatório que acomete a mucosa oral de crianças, podendo atingir gengiva, língua, lábios, palato e mucosa jugal.
Trata-se de uma condição multifatorial, associada a agentes infecciosos, traumas mecânicos, deficiências nutricionais ou reações imunológicas.
Em odontopediatria, é uma das afecções mais observadas na prática clínica, sendo caracterizada por lesões ulceradas, eritematosas e dolorosas, que causam desconforto e dificultam a alimentação.
A gravidade das manifestações varia conforme o agente etiológico, a idade e o estado imunológico do paciente.

Sintomas de estomatite infantil
Os sintomas podem variar conforme o tipo de estomatite, mas de forma geral incluem:
- Dor e ardência na mucosa bucal;
- Lesões ulceradas ou vesiculares;
- Gengiva edemaciada e hiperemiada;
- Dificuldade para mastigar ou engolir;
- Febre baixa a moderada;
- Irritabilidade e inapetência;
- Halitose e aumento da salivação.
Em casos mais severos, as lesões podem se disseminar por toda a cavidade oral e até pelo vermelhão labial, comprometendo significativamente o bem-estar da criança.

Como é feito o diagnóstico?
O diagnóstico da estomatite infantil é predominantemente clínico, baseado na anamnese detalhada e no exame físico minucioso.
O cirurgião-dentista deve investigar o histórico de febre, uso de medicamentos, episódios recorrentes de aftas, hábitos alimentares e presença de fatores irritantes locais.
Em casos de dúvida, exames complementares podem auxiliar:
- Cultura microbiológica: para identificar infecções bacterianas ou fúngicas;
- Exame citopatológico (Papanicolau bucal): útil para detectar infecções virais;
- Exames laboratoriais: para avaliar deficiências nutricionais ou distúrbios sistêmicos.
O diagnóstico diferencial deve incluir herpangina, doença mão-pé-boca, candidíase oral, aftas traumáticas e lesões herpéticas secundárias.
Causas da estomatite pediátrica
A etiologia da estomatite infantil é ampla e envolve fatores infecciosos, nutricionais, mecânicos e imunológicos.
A seguir, conheça as principais causas.
Vírus herpes simplex
A estomatite herpética primária é causada pelo vírus herpes simplex tipo 1 (HSV-1).
É altamente contagiosa e ocorre geralmente entre 6 meses e 5 anos.
As lesões iniciam como vesículas pequenas que evoluem para úlceras dolorosas, acompanhadas de febre e adenopatia submandibular.
O vírus permanece em estado de latência nos gânglios nervosos e pode reativar-se em situações de estresse, febre ou imunossupressão, gerando quadros recorrentes.

Infecções fúngicas
A candidíase oral é a infecção fúngica mais comum em crianças, causada pelo fungo Candida albicans.
Manifesta-se com placas esbranquiçadas aderentes à mucosa, que ao serem removidas deixam áreas eritematosas.
É frequente em lactentes, crianças imunossuprimidas ou após o uso prolongado de antibióticos e corticoides.
Infecções bactérias
Bactérias patogênicas como Streptococcus e Staphylococcus aureus podem provocar inflamações locais e ulcerações dolorosas, especialmente em casos de higiene oral deficiente ou imunidade comprometida.
Nesses quadros, a infecção secundária pode agravar lesões preexistentes.

Falta de higiene bucal
A ausência de cuidados adequados de higiene facilita a proliferação microbiana e aumenta a susceptibilidade a infecções.
Resíduos alimentares e biofilme acumulado na mucosa criam um ambiente propício para o desenvolvimento de agentes infecciosos, principalmente em crianças pequenas que ainda estão em fase de aprendizado de escovação.
Traumas na boca
Mordidas acidentais, uso inadequado de escovas, objetos colocados na boca e até próteses infantis mal adaptadas podem causar microtraumas que desencadeiam inflamação e ulceração local.
O trauma é um fator predisponente importante, especialmente em crianças com hábitos orais inadequados.

Reações alérgicas
Alguns alimentos, corantes, medicamentos ou produtos de higiene bucal podem provocar reações alérgicas locais, levando à inflamação e surgimento de lesões ulceradas.
O controle depende da identificação e remoção do agente irritante.
Estomatite aftosa recorrente (EAR)
A EAR é uma condição de etiologia multifatorial, caracterizada por aftas dolorosas que se repetem periodicamente.
Fatores imunológicos, genéticos, hormonais e emocionais estão entre os desencadeantes mais comuns.
As lesões podem ser únicas ou múltiplas, geralmente com bordas eritematosas e centro amarelado.

Deficiência nutricional
A carência de vitaminas do complexo B, ferro, zinco e ácido fólico pode reduzir a resistência da mucosa oral, tornando-a mais vulnerável a inflamações.
Crianças com dietas restritivas ou desequilibradas apresentam risco aumentado de desenvolver estomatite aftosa recorrente.
Como prevenir a estomatite?
A prevenção da estomatite infantil envolve uma combinação de medidas de higiene, nutrição e cuidado clínico:
- Manter higiene bucal adequada desde a erupção do primeiro dente;
- Estimular alimentação equilibrada, rica em vitaminas e minerais;
- Evitar o compartilhamento de utensílios e escovas dentais;
- Reduzir fatores de estresse e garantir boas noites de sono;
- Orientar os pais sobre o uso racional de medicamentos e antibióticos;
- Promover acompanhamento odontológico periódico, principalmente em crianças com episódios recorrentes.

Como é feito o tratamento?
O tratamento deve ser individualizado, considerando o tipo e a causa da estomatite.
O foco é aliviar os sintomas, controlar a infecção e prevenir recidivas.
Analgésicos e antitérmicos
Indicados para controle da dor e febre, os analgésicos e antitérmicos de uso pediátrico, como o paracetamol e o ibuprofeno, podem ser utilizados conforme orientação profissional.
O uso indiscriminado deve ser evitado, e sempre respeitadas as doses recomendadas de acordo com o peso corporal.
Pomadas anestésicas
O uso de pomadas tópicas com anestésicos locais, como lidocaína ou benzocaína, ajuda a aliviar a dor durante a alimentação e a escovação.
Devem ser aplicadas em pequena quantidade e sob orientação odontológica, evitando risco de toxicidade.

Antifúngicos e antivirais
Nos casos de candidíase, são indicados antifúngicos como nistatina ou miconazol.
Para estomatite herpética, antivirais como o aciclovir são eficazes na redução da duração e severidade das lesões, especialmente se administrados nas primeiras 72 horas após o início dos sintomas.
Alimentação adequada e hidratação
Durante o tratamento, é importante garantir hidratação constante e preferir alimentos frios e de consistência pastosa, que não irritem as mucosas.
Dessa forma, alimentos ácidos, condimentados ou muito quentes devem ser evitados.

Quando procurar um dentista?
A avaliação odontológica é fundamental sempre que houver lesões persistentes por mais de sete dias, dor intensa, febre alta ou sinais de infecção secundária.
O cirurgião-dentista tem papel central no diagnóstico precoce e no manejo clínico adequado, evitando complicações e garantindo conforto à criança.
Além disso, é importante orientar pais e cuidadores sobre o caráter não contagioso de algumas formas de estomatite, como a aftosa recorrente, e sobre o risco de transmissão viral em casos herpéticos.

Conclusão
A estomatite infantil é uma condição frequente na odontopediatria e exige do profissional atenção ao diagnóstico diferencial e domínio das condutas terapêuticas mais atuais.
Reconhecer os sinais precoces e orientar adequadamente os responsáveis são passos essenciais para um tratamento eficaz e humanizado.
Na EAP Goiás, o cirurgião-dentista encontra cursos que aprofundam temas como este, com foco em atualização científica e prática clínica avançada.
Há mais de 40 anos, a instituição atua na formação e aperfeiçoamento de profissionais comprometidos com a excelência odontológica.
Se você deseja aprimorar seus conhecimentos e se destacar no mercado, conheça os Cursos de Especialização da EAP Goiás e descubra as diversas opções disponíveis.
Transforme sua carreira com uma formação de alto padrão e compromisso com a qualidade!
Referências:
https://tuasaudebucal.com.br/estomatite-infantil-o-que-e-causas-sintomas-tratamentos-e-prevencao
https://www.tuasaude.com/estomatite-infantil
https://mdbf.com.br/artigo/estomatite-infantil
https://www.odontologianews.com.br/blog/2025/09/09/estomatite-pediatrica-5/
*O texto acima não foi escrito por cirurgião dentista, portanto a EAP não se responsabiliza pelas informações, uma vez que não possuem caráter científico.
